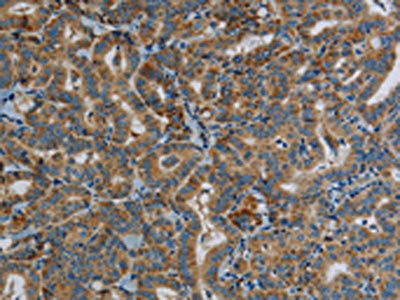

PPARGC1B Antibody
-
中文名稱:PPARGC1B兔多克隆抗體
-
貨號:CSB-PA012670
-
規格:¥1100
-
圖片:
-
The image on the left is immunohistochemistry of paraffin-embedded Human thyroid cancer tissue using CSB-PA012670(PPARGC1B Antibody) at dilution 1/30, on the right is treated with synthetic peptide. (Original magnification: ×200)
-
The image on the left is immunohistochemistry of paraffin-embedded Human brain tissue using CSB-PA012670(PPARGC1B Antibody) at dilution 1/30, on the right is treated with synthetic peptide. (Original magnification: ×200)
-
-
其他:
產品詳情
-
Uniprot No.:
-
基因名:PPARGC1B
-
別名:PERC antibody; peroxisome proliferative activated receptor, gamma, coactivator 1, antibody; peroxisome proliferator-activated receptor gamma coactivator 1 beta antibody; Peroxisome proliferator-activated receptor gamma coactivator 1-beta antibody; peroxisome proliferator-activated receptor gamma, coactivator 1 beta antibody; PGC-1(beta) antibody; PGC-1-beta antibody; PGC-1-related estrogen receptor alpha coactivator antibody; PGC1 antibody; PPAR gamma coactivator-1beta antibody; PPAR-gamma coactivator 1-beta antibody; PPARGC-1-beta antibody; PPARGC1 antibody; Ppargc1b antibody; PRGC2_HUMAN antibody
-
宿主:Rabbit
-
反應種屬:Human
-
免疫原:Synthetic peptide of Human PPARGC1B
-
免疫原種屬:Homo sapiens (Human)
-
標記方式:Non-conjugated
-
抗體亞型:IgG
-
純化方式:Antigen affinity purification
-
濃度:It differs from different batches. Please contact us to confirm it.
-
保存緩沖液:-20°C, pH7.4 PBS, 0.05% NaN3, 40% Glycerol
-
產品提供形式:Liquid
-
應用范圍:ELISA,IHC
-
推薦稀釋比:
Application Recommended Dilution ELISA 1:2000-1:5000 IHC 1:50-1:200 -
Protocols:
-
儲存條件:Upon receipt, store at -20°C or -80°C. Avoid repeated freeze.
-
貨期:Basically, we can dispatch the products out in 1-3 working days after receiving your orders. Delivery time maybe differs from different purchasing way or location, please kindly consult your local distributors for specific delivery time.
-
用途:For Research Use Only. Not for use in diagnostic or therapeutic procedures.
相關產品
靶點詳情
-
功能:Plays a role of stimulator of transcription factors and nuclear receptors activities. Activates transcriptional activity of estrogen receptor alpha, nuclear respiratory factor 1 (NRF1) and glucocorticoid receptor in the presence of glucocorticoids. May play a role in constitutive non-adrenergic-mediated mitochondrial biogenesis as suggested by increased basal oxygen consumption and mitochondrial number when overexpressed. May be involved in fat oxidation and non-oxidative glucose metabolism and in the regulation of energy expenditure. Induces the expression of PERM1 in the skeletal muscle in an ESRRA-dependent manner.
-
基因功能參考文獻:
- the KAT4 promoter was significantly activated by the transcriptional factors, NFE2related factor 2 and peroxisome proliferatoractivated receptor coactivator 1beta, which are targets of Syvn1induced degradation PMID: 29916549
- Incrementally paced murine Pgc1beta(-/-) hearts show pro-arrhythmic atrial phenotypes that are age dependent. PMID: 28960529
- Insulin-like growth factor 1 receptor, associate of Myc 1, and peroxisome proliferator-activated receptor gamma coactivator 1beta are direct targets of miR-139 PMID: 26868851
- Study provides evidence that PGC1beta rs32579 was associated with nevus count, and both melanoma risk and mortality, which further emphasizes the critical role of PGC1s in multiple steps of melanocyte formation and melanoma development. PMID: 28542949
- The presence of the PPARGC1B (Ala203Pro) SNP did not modify the association between inorganic arsenic methylation capacity and breast cancer. PMID: 27557380
- Genetic variants of PPARGC1B are significantly associated with gout, and a missense single nucleotide polymorphism, rs45520937, augments NLRP3 and IL-1beta expression PMID: 28394398
- the forkhead box O3 (FOXO3)/liver kinase B1 (LKB1)/AMP-activated protein kinase/peroxisome proliferator-activated receptor-gamma co-activator-1beta (PGC-1beta)/pyruvate dehydrogenase-A1 pathway is essential for CD44 expression and cancer stem cells properties. PMID: 28507102
- We also suggest a novel hepatic protective role of PGC1B as a modulator of E2 effects on mitochondrial biogenesis PMID: 27885055
- we show an association of HER2-overexpression and PGC-1beta. PGC-1beta knockdown impairs HER2-overexpressing cells proliferation acting on ERRalpha signaling, metabolism, and redox balance. PMID: 26602383
- Further replication study confirmed the association signals of rs4705372 (P = 0.0026) and rs11743128 (P = 0.0387) in the independent validation sample. Our study results suggest that PPARGC1B is a novel susceptibility gene of Kashin-Beck disease . PMID: 27108113
- Human influenza hemagglutinin-tagged PPARGC1B coprecipitated more intensely with ERalpha in the +102525A than the +102525G construct after 17beta estradiol treatment PMID: 27027322
- Data suggest that PGC-1alpha and PGC-1beta could play a role in regulating retina cell survival, and may be therapeutic targets to prevent retinal degeneration. PMID: 26427438
- PGC-1(beta) and estrogen-related receptor alpha are aberrantly expressed in human colon cell lines and tumors. PMID: 26351140
- RUNX3 is related to both the severity of AS and the function of daily life. PPARGC1B is related to the function of daily life. PMID: 25494292
- Data show that PGC-1beta protein mediated the expression of proinflammatory cytokines and apoptosis through extracellular signal-regulated kinase (ERK), p38 and NF-kappaB in rheumatoid arthritis fibroblast-like synoviocytes. PMID: 25367151
- Variation in the PPARGC1B gene may be associated with type 2 diabetes among middle-aged Chinese men and women. PMID: 24359475
- cell apoptosis is orchestrated by the balance between several signaling pathways, and PGC-1beta takes part in these events in breast cancer cells mediated by the mTOR signaling pathway. PMID: 23877360
- PPARgamma and PPARGC1B polymorphisms modulate the association between phthalate exposure and BC risk PMID: 23866026
- DNA polymorphisms of PPARGC1B, coding a bona fide ER co-activator, are associated with ER-positive breast cancer risk. PMID: 21269472
- PGC-1b, a coactivator of both LXR-alpha and SREBP-1, was markedly down-regulated by OEPAs compared with EPA. PMID: 23680128
- PPARGC1B is associated with the susceptibility to ankylosing spondylitis in the Chinese Han population. PMID: 23637848
- PGC-1beta mediates adaptive chemoresistance to cisplatin associated with mitochondrial DNA mutations in non-small-cell lung cancer cells. PMID: 22777349
- Peroxisome proliferator-activated receptor gamma coactivator 1beta (PGC-1beta) protein attenuates vascular lesion formation by inhibition of chromatin loading of minichromosome maintenance complex in smooth muscle cells PMID: 23264620
- Inhibition of PGC-1a and PGC-1b blocks the alpha-MSH-mediated induction of MITF and melanogenic genes. PMID: 23201126
- Absence of PGC-1 proteins accelerated the transition to heart failure following pressure overload. PMID: 22939990
- Acetyl-L-carnitine activates the peroxisome proliferator-activated receptor-gamma coactivators PGC-1alpha/PGC-1beta-dependent signaling cascade of mitochondrial biogenesis and decreases the oxidized peroxiredoxins content in old rat liver PMID: 22533417
- Polymorphisms of -427C>T on the promoter and those of +102525G>A on exon 5 of the PPARGC1B gene may affect the development of AHR through the modulation of PPARGC1B gene products. PMID: 21692888
- Exercise can activate an upstream promoter in humans and support AMPK as a major regulator of transcripts from the canonical PGC-1alpha promoter and the involvement of beta-adrenergic stimulation in combination with AMPK in the regulation of PGC-1alpha-b. PMID: 21862727
- PGC-1beta is a potent regulator of angiogenesis, thus providing a novel link between the regulations of oxidative metabolism and vascular density. PMID: 21364124
- Data show that mitogen-activated protein kinase kinases direct mitochondrial biogenesis by selectively inducing PGC-1beta expression. PMID: 21458501
- physiological role of PGC-1beta: investigation of mitochondrial homeostasis regulatory pathway involving PGC-1beta and PI3K; investigation of regulation of PGC-1beta gene expression PMID: 21054343
- miR-378( *) inhibits the expression of two PGC-1beta partners, ERRgamma and GABPA, leading to a reduction in TCA cycle gene expression and oxygen consumption as well as an increase in lactate production and in cell proliferation PMID: 20889127
- Taken together, these results confirm the direct interaction of NRF-1 and ERR alpha with PGC-1 beta, and their participation in mitochondrial biogenesis and respiration. PMID: 20561910
- the PPARGC1B gene Ala203Pro polymorphism is associated with physical performance of athletes. PMID: 20058823
- The PGC-1-related protein PERC is a selective coactivator of estrogen receptor alpha PMID: 11854298
- role in coactivating the cardiac-enriched nuclear receptors estrogen-related receptor-alpha and -gamma PMID: 12181319
- role in activating orphan nuclear constitutive androstane receptor PMID: 12551939
- Variation of PGC-1beta may contribute to the pathogenesis of obesity, with a widespread Ala203 allele being a risk factor for the development of this common disorder. PMID: 15863669
- fatty acids differentially regulated expression of the genes encoding the PGC-1B isoform PMID: 16132959
- PPARGC1A, PPARGC1B, and EP300 may have roles for familial breast cancer susceptibility PMID: 16704985
- Acute elevation of plasma non-esterified fatty acd levels downregulates PPARGC1A, PPARGC1B and PPARA expression. PMID: 16896940
- Recent studies have elucidated the function of the PGC-1 coactivators in different tissues and have highlighted the implications of PGC-1 dysregulation in diseases such as diabetes, obesity, cardiomyopathy, or neurodegeneration. PMID: 17018837
- Upregulation of PGC-1alpha and PGC-1beta in the colorectal tumor cells can be part of an adaptation mechanism to help overcome the severe consequences of mtDNA mutations on oxidative phosphorylation. PMID: 17341490
- Study suggests that young carriers of a PGC-1beta 203Pro allele have enhanced insulin-stimulated glucose metabolism and may be protected against an age-related decline in PGC-1beta expression in muscle. PMID: 17579828
- training caused a decrease in PGC-1beta mRNA levels. PMID: 17690194
- A novel role of PGC-1beta in mitochondrial physiology, namely the control of mitochondrial fusion mainly through Mfn2. PMID: 18974884
- the association of the 482G/A polymorphism of the PGC-1alpha gene with type 2 diabetes and the quantitative and qualitative binding force changes between the PGC-1alpha domain mutant and MEF2C PMID: 19065516
- PGC-1alpha and PGC-1beta expression improved mitochondrial respiration in cells from patients with mitochondrial disorders. PMID: 19297390
- PGC-1beta is a substrate for general control of amino-acid synthesis (GCN5) and is acetylated on at least 10 lysine residues that are distributed along multiple domains of the protein. PMID: 19491097
顯示更多
收起更多
-
亞細胞定位:Nucleus.
-
組織特異性:Ubiquitous with higher expression in heart, brain and skeletal muscle.
-
數據庫鏈接:
Most popular with customers
-
-
YWHAB Recombinant Monoclonal Antibody
Applications: ELISA, WB, IHC, IF, FC
Species Reactivity: Human, Mouse, Rat
-
Phospho-YAP1 (S127) Recombinant Monoclonal Antibody
Applications: ELISA, WB, IHC
Species Reactivity: Human
-
-
-
-
-